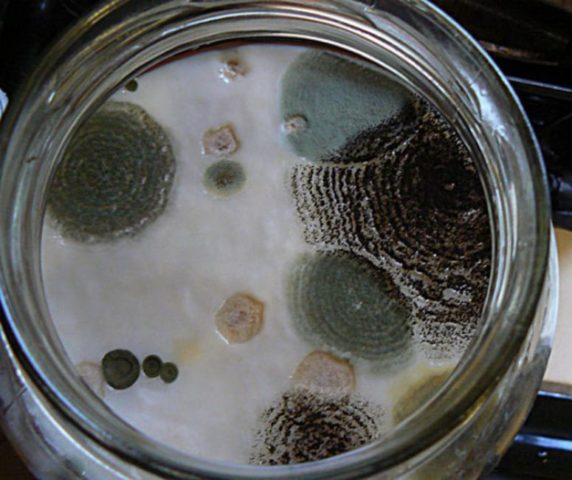

Contenido
Salar y encurtir los champiñones de leche en frío y, a veces, en caliente siempre está plagado de un problema: la aparición de moho. Sin embargo, esta no siempre es una frase para la tarea. Si los champiñones de leche salados o en escabeche tienen moho, con una detección temprana se pueden salvar.
¿Por qué apareció moho después de salar los champiñones?
Los mohos son el organismo vivo más común en la tierra. En un entorno confortable, se reproducen con bastante rapidez y se extienden a más y más territorios nuevos. Los hongos enlatados son una excelente base de nutrientes para el crecimiento de moho. Es suficiente incluso que una pequeña cantidad de esporas de moho ingrese en un recipiente donde se almacenan los hongos de leche salados o en escabeche, esto ciertamente conducirá a la propagación del foco de infección a todos los productos, sin excepción, en el frasco.

Moho en los champiñones: el resultado de violaciones durante el enlatado y el almacenamiento.
Hay bastantes razones por las que los champiñones con leche salados se vuelven mohosos incluso en frascos enrollados con fuerza debajo de una tapa de metal. Estos son los principales:
- Tratamiento térmico insuficiente (con enlatado caliente).
- Materias primas sucias.
- Baja cantidad de conservantes como sal o vinagre.
- Mala preparación de los envases para conservas, esterilización insuficiente de las latas.
- Torsión floja de latas, violación de su estanqueidad durante el almacenamiento.
- Condiciones de almacenamiento inaceptables.
¿Es posible comer setas de leche salada?
El oxígeno es esencial para el desarrollo del moho. Por lo tanto, los hongos crecen enmohecidos en primer lugar en el lugar donde hay contacto directo del cuerpo fructífero con el aire. A partir de esto, los cuerpos frutales se vuelven negros y aparece una flor de color blanco verdoso en su superficie. No se pueden comer de esta forma. Las capas más profundas de las tapas, ocultas bajo la salmuera, se moldean mucho más tarde. Si los hongos de leche están mohosos desde arriba, entonces es necesario deshacerse de toda la capa superior que tiene rastros de daño. Debajo puede haber hongos salados absolutamente normales. Si realiza una serie de manipulaciones con ellos, entonces pueden comerse de forma segura sin ningún miedo.
Gravemente afectado por hongos de moho en una dirección: a la basura
Qué hacer con el moho en los champiñones con leche salada.
Habiendo descubierto que los hongos de leche salada tienen moho, es necesario comenzar a procesarlos lo antes posible. En este caso, lo más probable es que se guarde la mayor parte de la tarea. La capa superior de hongos de leche, en la que hay negrura y rastros obvios de desarrollo de moho, debe desecharse sin dudarlo. Si debajo hay tapas limpias y sin daños, deben transferirse con cuidado a otro recipiente. Dado que las esporas de moho ya están presentes en la salmuera, todos los cuerpos fructíferos eliminados deben hervirse para evitar un mayor desarrollo del hongo.
Una cacerola con pesos limpios seleccionados se vierte con agua limpia y se prende fuego. Hacer hervir el agua es suficiente para matar las esporas de moho. Después de hervir, se drena el agua.Los hongos se colocan en recipientes esterilizados, se espolvorean con sal y se vierten con salmuera fresca.

Hervir matará las esporas de moho en la salmuera
Es necesario desinfectar no solo el recipiente en el que se colocan los hongos de leche, sino también un círculo de madera y opresión, que mantiene los hongos en la salmuera. Se lavan a fondo del moho con agua y luego se escaldan con agua hirviendo. La taza y la opresión se colocan en su lugar, después de lo cual se retira el recipiente para su almacenamiento.
Reglas de almacenamiento para setas de leche salada.
Lo mejor de todo es que los champiñones con leche se almacenan a una temperatura de + 2-4 ° C. A medida que aumenta, el riesgo de que se vuelva a desarrollar moho aumenta significativamente. Para evitar esto, la bañera se inspecciona periódicamente. Aproximadamente 1 vez por semana, se quitan la opresión y el círculo de madera, la salmuera, que está por encima del nivel de los hongos, se drena cuidadosamente, agregando solución salina fresca en su lugar. Los bordes de la tina se limpian con un paño humedecido en vinagre. El círculo de madera y la opresión se lavan con agua y se escaldan con agua hirviendo, después de lo cual se devuelven a su lugar.

Cuando se almacena en las condiciones adecuadas, el riesgo de crecimiento de moho en la leche salada es muy pequeño.
En el video puedes ver cómo se controla el desarrollo de moho al salar setas:
Conclusión
Si durante el almacenamiento los champiñones de leche salada se enmohecen, no es motivo para tirarlos. Basta con descartar, desinfectar el recipiente y los propios hongos y llenarlos con salmuera fresca. Y para evitar una repetición del problema, durante una inspección detallada, se debe establecer la causa de la aparición del moho, se deben verificar las condiciones de almacenamiento, la calidad de las materias primas y los materiales utilizados.